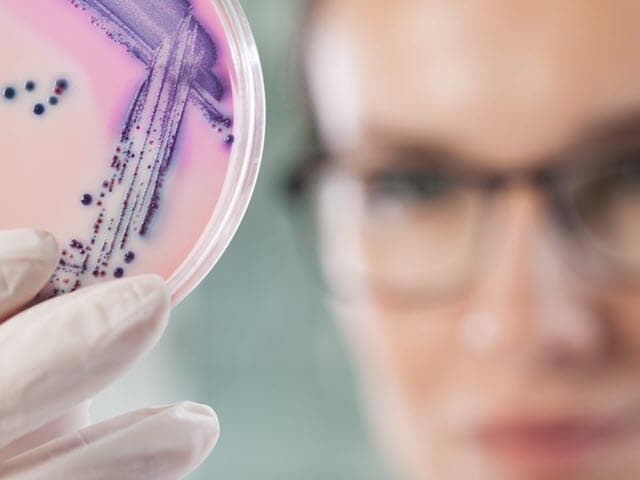
pharma-cmc-product-development-microbiological-480x640

Pharmaceutical Testing Services
Element leads the way in pharmaceutical testing services, delivering trusted expertise from prototype to analysis and finished product. With 150+ global pharmaceutical experts, we offer accurate, efficient, and cost-effective testing tailored to your regulatory needs. Backed by 30+ years of experience, Element ensures quality, compliance, and speed - so you can bring your product to market with confidence
Why Element are global leaders in the Pharmaceutical Testing Industry
From prescription drugs, biologics, and nutraceuticals to combination drug-device products - we know pharmaceutical manufacturers need reliable testing partners to ensure compliance and safety amidst increasing pressure to bring innovative products to market quickly, while navigating complex regulatory requirements and maintaining strict quality standards.
Element has established a proud track record at the forefront of pharmaceutical testing, providing specialized services through our global laboratory network. We understand that successful product quality verification requires precise testing and reliable results, which is why we deliver accurate analytical data that helps you meet regulatory requirements and accelerate your timelines. By partnering with Element, you'll experience peace of mind during your development and testing process, with expert guidance, transparent communication, and phase-appropriate solutions tailored to your needs. Your intellectual property remains secure and any test methods or technology we develop stays within your ownership.
Services

Biopharmaceuticals & Biologics Analysis Services
Our clients develop safe, efficacious products with confidence thanks to Element’s Biologics and Advanced Therapy Medicinal Products (ATMPS) testing services.

Biosimilar Development & Testing Services
Element's biosimilar testing services support every stage of development, providing expert analysis and regulatory guidance to streamline the 351(k) approval process and bring safe, effective biosimilars to market.

Cell Culture & Cell-Based Bioassay Services
Element provides expert cell-based bioassay services, including potency testing, method validation, and regulatory support, helping biopharmaceutical companies streamline drug development and approval.

Gene Therapy Process Development & Manufacturing Support Services
We can help you accelerate your gene therapy development while reducing costs and ensuring patient safety. Our gene therapy process development and analytical methods support helps you overcome development challenges and meet regulatory requirements faster. We integrate QC-centric method development with comprehensive analytical testing to streamline your path from discovery to manufacturing.

Monoclonal Antibody (mAb) Characterization & Analysis services
Element's industry-leading expertise, methods, and purpose-built laboratories help to guide a steady, efficient path through regulatory approval for monoclonal antibody (mAb) therapies, the fastest-expanding class of protein therapeutics.

Therapeutic Peptide Analysis Services
Element's advanced technologies and understanding of biological chemistry will help you characterize and optimize your therapeutic peptide programs.

Therapeutic Enzymes & Protein Analysis
Element provides expert therapeutic protein analysis, offering tailored bioanalytical testing to support IND and BLA regulatory pathways. Our services optimize stability, purity, and efficacy for therapeutic proteins and enzymes.

California Proposition 65 Compliance for Manufacturers and Distributors
Element provides California Prop 65 compliance testing for manufacturers and distributors, helping identify hazardous chemicals, assess exposure risks, and determine labeling obligations to meet regulatory requirements and reduce legal exposure.

Chemistry, Manufacturing and Controls (CMC) & CDMO Testing Services
Element provides specialized analytical testing services designed for CDMOs, offering flexible capacity, regulatory compliance, and advanced capabilities that enable successful client program delivery across all development phases.
Microbiological Development and Quality Control Testing Services
Element's lab provides specialist microbiology testing services and quality control for drug products that support all phases of product and process development and help to maintain product integrity.

Drug Discovery and Development
Element's CDMO services offer tailored drug discovery and development solutions, helping you reduce costs, accelerate timelines, and advance clinical trials with expert support at every stage.

Stability and Forced Degradation Testing of Pharmaceuticals and Biologics
ICH-compliant pharmaceutical and biologics stability and forced degradation testing with advanced analytics, specialized storage, and regulatory support—designed to reduce risk and support successful drug development and submissions.

Premier Molecular Studies and Testing Services
As a premier provider of molecular studies and testing services, Element delivers accurate and reliable results. Our CLIA-certified reference molecular lab is trusted to provide comprehensive molecular characterization of isolates.

Reference Standard Characterization and Management
Element offers pharmaceutical reference standard management, delivering tailored characterization, validation, and storage solutions to meet regulatory requirements and enhance product quality for small molecules, biologics, and biosimilars.

Cleaning Validation & Verification Services
Element offers pharmaceutical cleaning validation and verification services to help manufacturers meet regulatory requirements, prevent contamination, and streamline processes for safe and compliant drug production.

Compendial Monograph and Pharmacopeial Testing
Element provides expert compendial testing services to help pharmaceutical and biotech companies meet global pharmacopeial standards, ensuring product quality, compliance, and market readiness.

Compounding Pharmacies
Element provides expert testing and environmental monitoring services for sterile compounding facilities, addressing contamination risks and regulatory compliance while enabling you to focus on patient care.

Environmental Monitoring Services
Element offers tailored pharmaceutical environmental monitoring services, helping maintain cleanroom control and regulatory compliance while protecting product quality and patient safety.

Extractables and Leachables Testing Services
Element provides tailored extractables and leachables testing (E&L) studies to ensure patient safety and compliance with regulatory requirements.

GMP Lot Release Testing Services
Comprehensive GMP lot release testing services for pharmaceutical and biologic products. Expert scientists, advanced labs, and tailored solutions to meet rigorous quality and compliance standards globally.

Material Sciences Testing
Our material testing laboratories provide a complete suite of material testing services for pharmaceutical companies.

Nuclear Magnetic Resonance (NMR) Spectroscopy in Pharmaceutical Analysis
Element's Nuclear Magnetic Resonance (NMR) Spectroscopy analysis supports critical stages of pharmaceutical development, enabling verification of chemical synthesis and compound characterization.

Chemical Characterization
Element's chemical characterization services help identify, analyze, and ensure the quality of materials, addressing challenges in purity, composition, and contaminants with advanced techniques and expertise.

Particle Size Distribution (PSD) Testing and Analysis
Element's experts provide specialist particle analysis services for Particle Size Distribution (PSD) and particle counting following USP, EP, ASTM and ISO methods.

Contaminant Analysis and Complaints Investigations
Our contamination detection and analysis services isolate and identify unknown particulates and contaminants in pharmaceuticals and biologics down to trace levels.

Pharmaceutical XRD Testing
Element's pharmaceutical XRD testing delivers precise crystalline structure analysis with minimal sample requirements. Our advanced equipment and 30+ years of expertise help you meet regulatory requirements faster. Contact our experts today.

Rubber, Polymer, & Plastic Testing
Element offers tailored rubber, polymer, and plastic testing services, supporting quality control, failure analysis, and product development with advanced techniques and expert insights for pharmaceuticals.

Physical and Mechanical Testing of Polymers for Pharmaceuticals
Element offers tailored rubber, polymer, and plastic testing services, supporting quality control, failure analysis, and product development with advanced techniques and expert insights for pharmaceuticals.

Physical Characterization of Pharmaceutical Products services
Our expert physical characterization scientists apply a variety of techniques, from SEM to TGA, to help you understand the physical properties of your pharmaceutical materials.

Solid-State Characterization of Active Pharmaceutical Ingredients (APIs) and Excipients
Element's solid-state characterization services streamline drug development, improving API performance, stability, and manufacturability. Our tailored strategies and expert teams address key pharmaceutical challenges for faster results.

Pharmaceutical Medical Device and Product Testing
With Element as your medical device testing partner, you’ll enjoy the benefit of a single comprehensive supplier across feasibility, R&D and prototype trials, through product development, regulatory validation and production quality control.

510(k) Testing & Consulting
Successful FDA 510(k) submissions are critical to your market success. Incomplete or inaccurate submissions can lead to failure and may delay your product launch. Our Engaged Experts are ready to assist.

Hand Sanitizer Efficacy Testing
Element offers complete hand sanitizer efficacy testing, including USP 611 GC-FID and GC-MS methods, to verify alcohol content, purity, and safety, helping products meet regulatory standards.

Medical Grade Polymer Testing
Comprehensive medical grade polymer testing to support device development, improvement, and compliance with regulatory standards. Tailored solutions address safety, quality, and performance needs in medical devices.

Polymeric Failure Analysis Services for Medical Devices
Element's experts provide failure analysis of polymer-based medical devices, which is critical to ensuring that process or material improvements can be made to prevent repeated failures.

Analytical Method Development & Validation
Element's regulatory and industry experts have a proven track record of successfully developing and validating fit-for-purpose, accurate, and reliable analytical methods based on established CDER/ICH and FDA guidelines and procedures.

Rapid Sterility and Mycoplasma Solutions
Element provides reliable rapid mycoplasma and sterility testing and delivers results in a matter of days.

Raw Materials and Excipients Testing Services
Element offers expert raw material and excipient testing services, addressing pharma industry challenges with advanced techniques to support quality, safety, and regulatory compliance throughout drug development and manufacturing.

Pharmaceutical Container & Packaging Testing
Element provides professional testing services for containers, container closures, and pharmaceutical packaging on polymers and glass containers to several pharmacopeia methods.

JMI SENTRY Antimicrobial Surveillance Program
SENTRY Antimicrobial Surveillance tracks global resistance patterns using advanced methods and a vast network of medical centers, supporting drug development and monitoring with over 20 years of expertise.

Trace Metal Testing and Analysis Services
Element offers trace metal testing and impurity analysis services, addressing safety, compliance, and contamination challenges for pharmaceutical products with advanced techniques and global expertise.

Elemental Impurities Testing and Analysis
Industry-leading elemental impurities testing for pharmaceuticals. Offering advanced methods, accurate trace detection, and regulatory expertise to support safe and compliant drug development processes.

Pharmaceutical Unknown Identification and Impurity Testing
Element offers expert impurity testing services for pharmaceuticals, ensuring drug safety, quality, and compliance with FDA and ICH guidelines through advanced analytical methods and tailored solutions.

Metals Speciation Analysis
Element offers advanced metal speciation analysis, providing detailed data on toxicity and bioavailability to support risk assessments in pharmaceuticals, biologics, and other industries.

USP 665, USP 1665 and BPOG Services
Element provides expert testing services for USP 665, USP 1665, and BPOG standards, helping pharmaceutical companies manage compliance, safeguard patient safety, and speed up regulatory approval.

Virology Testing
Element delivers GLP-compliant virology testing for antimicrobial products, helping companies meet global regulations, validate claims, and accelerate time to market with expert-led, reliable data.
- Biopharmaceuticals & Biologics Analysis Services
- Biosimilar Development & Testing Services
- Cell Culture & Cell-Based Bioassay Services
- Gene Therapy Process Development & Manufacturing Support Services
- Monoclonal Antibody (mAb) Characterization & Analysis services
- Therapeutic Peptide Analysis Services
- Therapeutic Enzymes & Protein Analysis
- California Proposition 65 Compliance for Manufacturers and Distributors
- Chemistry, Manufacturing and Controls (CMC) & CDMO Testing Services
- Microbiological Development and Quality Control Testing Services
- Drug Discovery and Development
- Stability and Forced Degradation Testing of Pharmaceuticals and Biologics
- Premier Molecular Studies and Testing Services
- Reference Standard Characterization and Management
- Cleaning Validation & Verification Services
- Compendial Monograph and Pharmacopeial Testing
- Compounding Pharmacies
- Environmental Monitoring Services
- Extractables and Leachables Testing Services
- GMP Lot Release Testing Services
- Material Sciences Testing
- Nuclear Magnetic Resonance (NMR) Spectroscopy in Pharmaceutical Analysis
- Chemical Characterization
- Particle Size Distribution (PSD) Testing and Analysis
- Contaminant Analysis and Complaints Investigations
- Pharmaceutical XRD Testing
- Rubber, Polymer, & Plastic Testing
- Physical and Mechanical Testing of Polymers for Pharmaceuticals
- Physical Characterization of Pharmaceutical Products services
- Solid-State Characterization of Active Pharmaceutical Ingredients (APIs) and Excipients
- Pharmaceutical Medical Device and Product Testing
- 510(k) Testing & Consulting
- Hand Sanitizer Efficacy Testing
- Medical Grade Polymer Testing
- Polymeric Failure Analysis Services for Medical Devices
- Analytical Method Development & Validation
- Rapid Sterility and Mycoplasma Solutions
- Raw Materials and Excipients Testing Services
- Pharmaceutical Container & Packaging Testing
- JMI SENTRY Antimicrobial Surveillance Program
- Trace Metal Testing and Analysis Services
- Elemental Impurities Testing and Analysis
- Pharmaceutical Unknown Identification and Impurity Testing
- Metals Speciation Analysis
- USP 665, USP 1665 and BPOG Services
- Virology Testing
Your Challenges, Our Solutions
Time-to-Market Pressure
Complex Regulatory Compliance
Quality Control Consistency
Products & Materials we test
- Active Pharmaceutical Ingredients (APIs)
- Raw materials and excipients
- Finished pharmaceutical products
- Biologics and ATMPs
- Plastics and polymers
- Parenteral and topical products
- Pharmaceutical containers
- Drug-device combinations
- Materials for pre-clinical and clinical trials
Why Choose Element

Extensive Expertise Network
Comprehensive Solutions
Efficient Testing Partnership
Quality Assurance Leadership
But don't just take our word for it
See what others have to say about partnering with Element
Overcome Development Resource Constraints with Pharmaceutical Research & Development Services
Creative outsourcing of your drug development activities with Element helps your organization bring new products to market in a timely and cost-effective manner. Our strong, agile approach as a contract research organization produces striking results while providing immediate access to advanced equipment and specialized expertise.
Services include:
- Chemistry, Manufacturing and Control (CMC) analytical testing
- Comprehensive analytical method development and validation
- Chemical and physical characterization services
- Analytical testing support for regulatory submissions
- Quality control and release testing
Speak to our team of experts
Text here 8bdb1ae8-a7e3-ef11-8ee9-6045bda94f09







